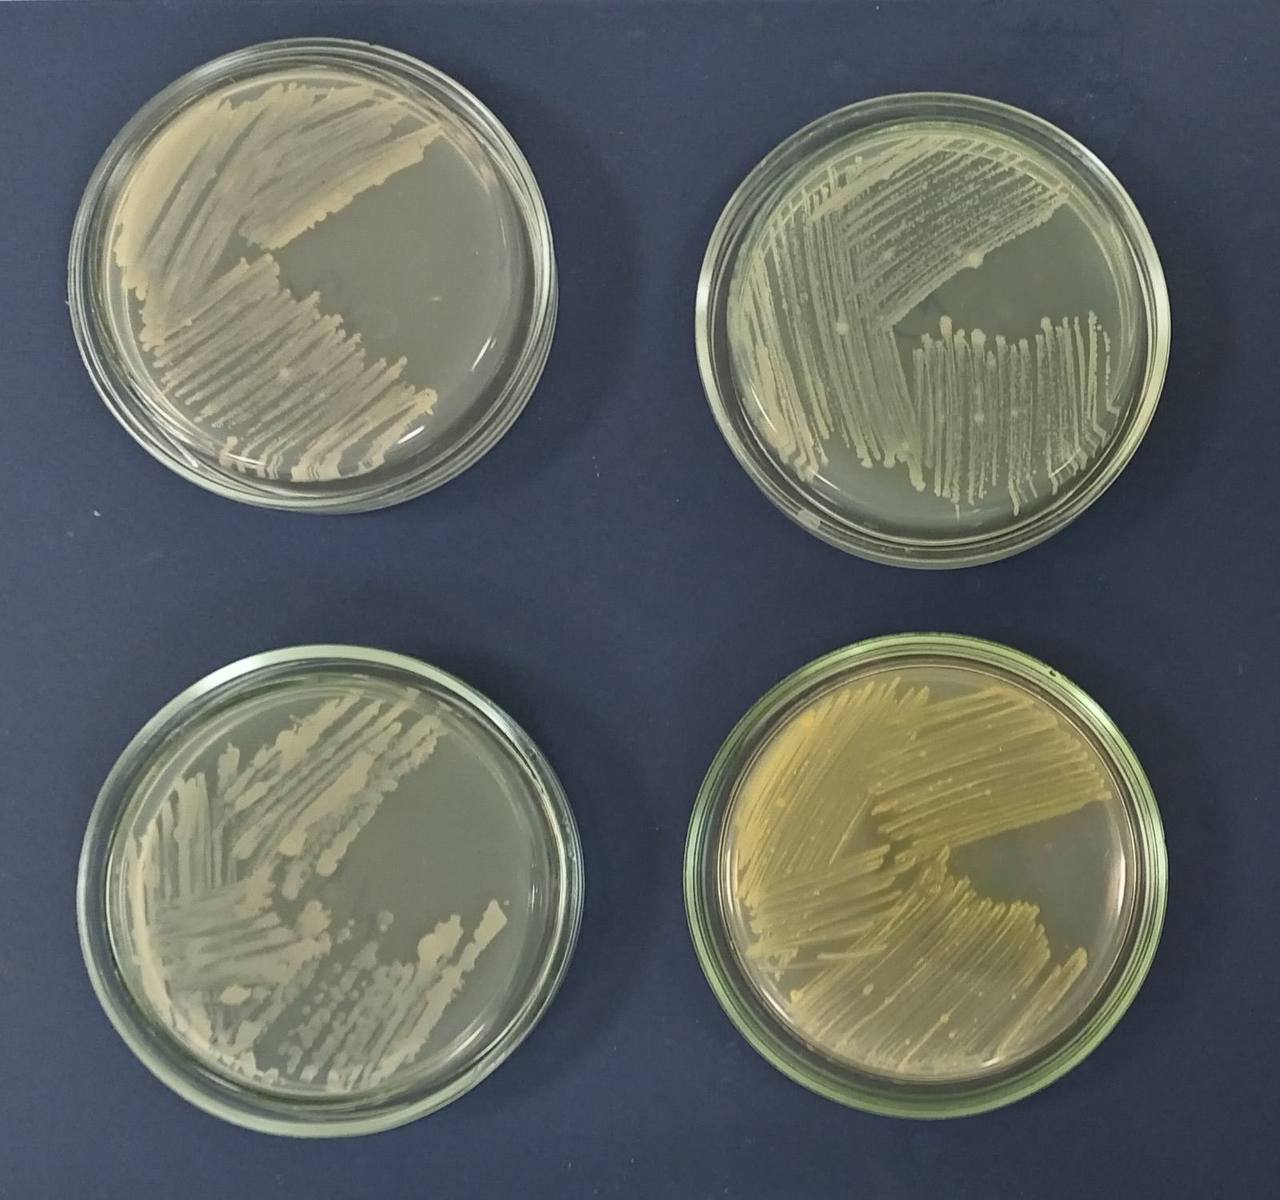
5
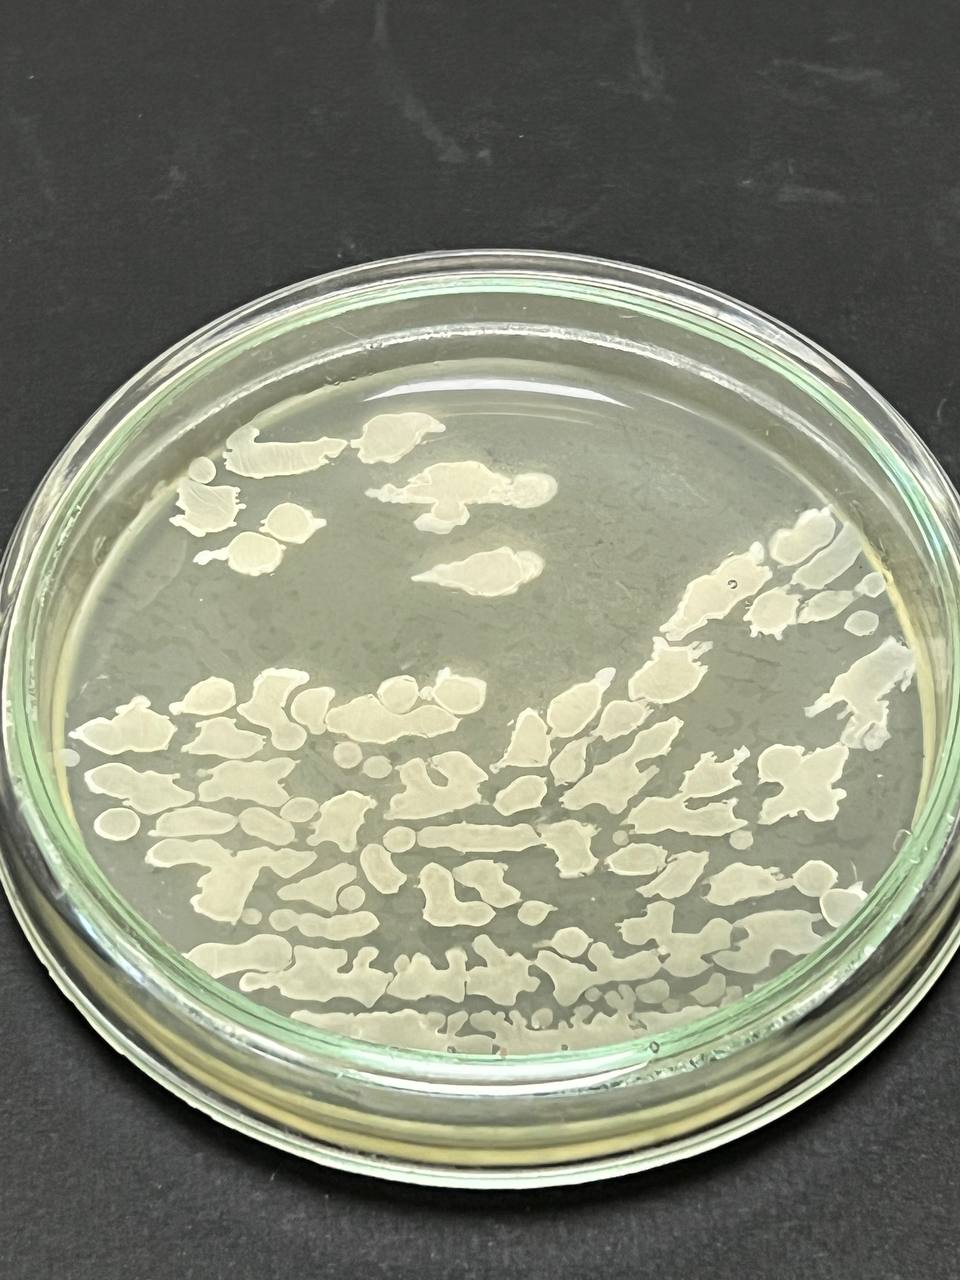
6

Навчальна лабораторія патології лісу ім. професора А.В. Цилюрика
На базі кафедри знаходиться навчальна лабораторія патології лісу імені професора А.В. Цилюрика, де проходять лекційні та лабораторно-практичні заняття, а також навчальні практики з ряду дисциплін для бакалаврів. Наукова спрямованість лабораторії пов’язана зі з’ясуванням чинників, що впливають на системну взаємодію автотрофів і гетеротрофів у формуванні біологічно стійких насаджень. Для подальшої роботи заплановано оновити застарілу технічну базу лабораторій кафедри, які використовуються для навчальної роботи та проведення науково-консультаційних робіт, покращення матеріально-технічної бази для забезпечення підготовки фахівців (обладнання робочих місць, наповнення лабораторій необхідним устаткуванням та приладами тощо).
![]() |
![]() |
![]() |
![]() |
![]() |
![]() |
![]() |
![]() |
![]() |